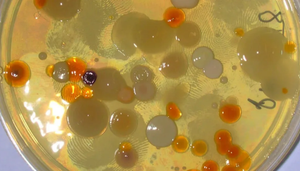
Độ lì kinh ngạc của vi khuẩn: Nhịn đói 1.000 ngày vẫn 'khỏe re'

Đình chỉ hoạt động cơ sở mầm non Elm School nghi bỏ đói, bạo hành trẻ
Cơ sở mầm non Elm School (Đà Nẵng) bị tạm đình chỉ để phục vụ điều tra vụ bỏ đói, bạo hành trẻ.

Cơ sở mầm non Elm School (Đà Nẵng) bị tạm đình chỉ để phục vụ điều tra vụ bỏ đói, bạo hành trẻ.
Một nghiên cứu được công bố trên tạp chí PNAS cho thấy, vi khuẩn có thể sống mà không cần thức ăn trong 1.000 ngày.

Do chạy từ miền Nam về quê tránh dịch, khi đến Hà Tĩnh, người đàn ông ngất xỉu bên vệ đường vì 3 ngày không ăn gì.

Uống quá nhiều nước trái cây, bỏ bữa, ăn ít chất béo hay tập thể dục quá sức là những cách giảm cân phản khoa học bạn cần tránh.

Ăn quá ít chất béo, bỏ bữa, cắt giảm nhóm thực phẩm, ăn kiêng hay tự bỏ đói bản thân là những cách giảm cân phản khoa học, hại sức khỏe bạn cần tránh.

Nhịn đói thường được xem là 1 trong những giải pháp giảm cân tiêu cực; tuy nhiên nghiên cứu mới nhất trình bày tại Hội nghị thường niên của Hội béo phì cuối năm 2016 cho thấy, nhịn đói theo 1 số giờ nhất định sẽ có tác dụng "tiêu" mỡ hiệu quả.

Bữa sáng là bữa ăn quan trọng nhất trong ngày, tuy nhiên, nhiều người Việt vẫn mắc sai lầm khi ăn sáng và điều này cực hại sức khỏe.

Những hình ảnh về người mẹ có dấu hiệu lạm dụng ma túy nhốt cậu bé là con ruột của mình trong một căn phòng ổ chuột, và không cho ăn, chỉ uống suốt một năm trời

Đến lúc hết tiền, Hà đóng giả cô gái 19 tuổi bị cơ nhỡ để lợi dụng lòng trắc ẩn, lừa lấy tiền của nhiều người dân.

(VTC News)- Món quà nhỏ độc giả VTC News gửi tặng sẽ chắp cánh ước mơ được tiếp tục đến trường của bé Bùi Thị Khánh.

(VTC News) - Trong cái rét đầu mùa kèm mưa lạnh thấu da, em bé mồ côi ở miền núi xứ Thanh vẫn phong phanh manh áo rách, chân không giầy dép đến lớp.

(VTC News) - Một cô gái nhịn đói trong suốt 20 năm để được trẻ đẹp đã biến thành một bộ xương khô vô cùng đáng thương.

(VTC News) - Khi 18 tuổi, chàng trai này chỉ nặng có 27 kg và suýt chết.